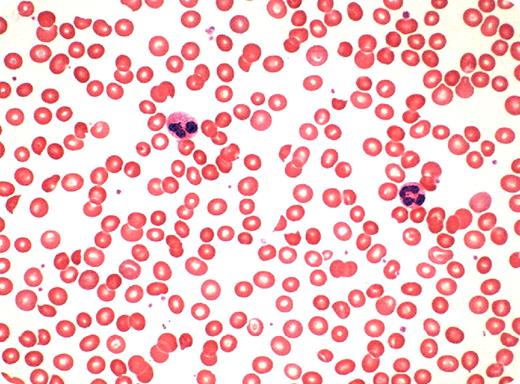

A 62-year-old woman was referred for mild anemia. She was postmenopausal with no previous history of anemia, bleeding, or jaundice. Family history of anemia was negative. Her past history included the placement of an artificial aortic heart valve a number of years earlier. Her medications included warfarin (prothrombin time was well regulated) and a small dose of aspirin daily. She had a systolic murmur at the upper sternum with sounds typical of an implanted heart valve. There was no evidence of congestive heart failure. Her nails were normal and the spleen was not palpable. Hemoglobin was 111 g/L and mean corpuscular volume was 77 fL; the rest of the complete blood count (CBC) was normal. Reticulocytes were normal. LDH was mildly elevated and renal and hepatic laboratory tests were normal. Stool was hemoccult negative.
Peripheral blood smear showed some microcytosis and an increased number of schistocytes. The white cells and platelets were normal. Other laboratory assessments showed evidence of early iron deficiency, a modest decrease in haptoglobin, and the presence of hemosiderin in the urine.
The presence of microcytosis in a patient on an anticoagulant and aspirin raised the suspicion of iron deficiency from blood loss. However, the presence of lowered haptoglobin, hemosiderinuria, and schistocytosis implicated chronic hemolysis. This is an example of traumatic (valve-associated) hemolytic anemia. Because she had no evidence of cardiovascular decompensation, the only treatment needed was iron replacement.
Many Blood Work images are provided by the ASH IMAGE BANK, a reference and teaching tool that is continually updated with new atlas images and images of case studies. For more information or to contribute to the Image Bank, visit www.ashimagebank.org.